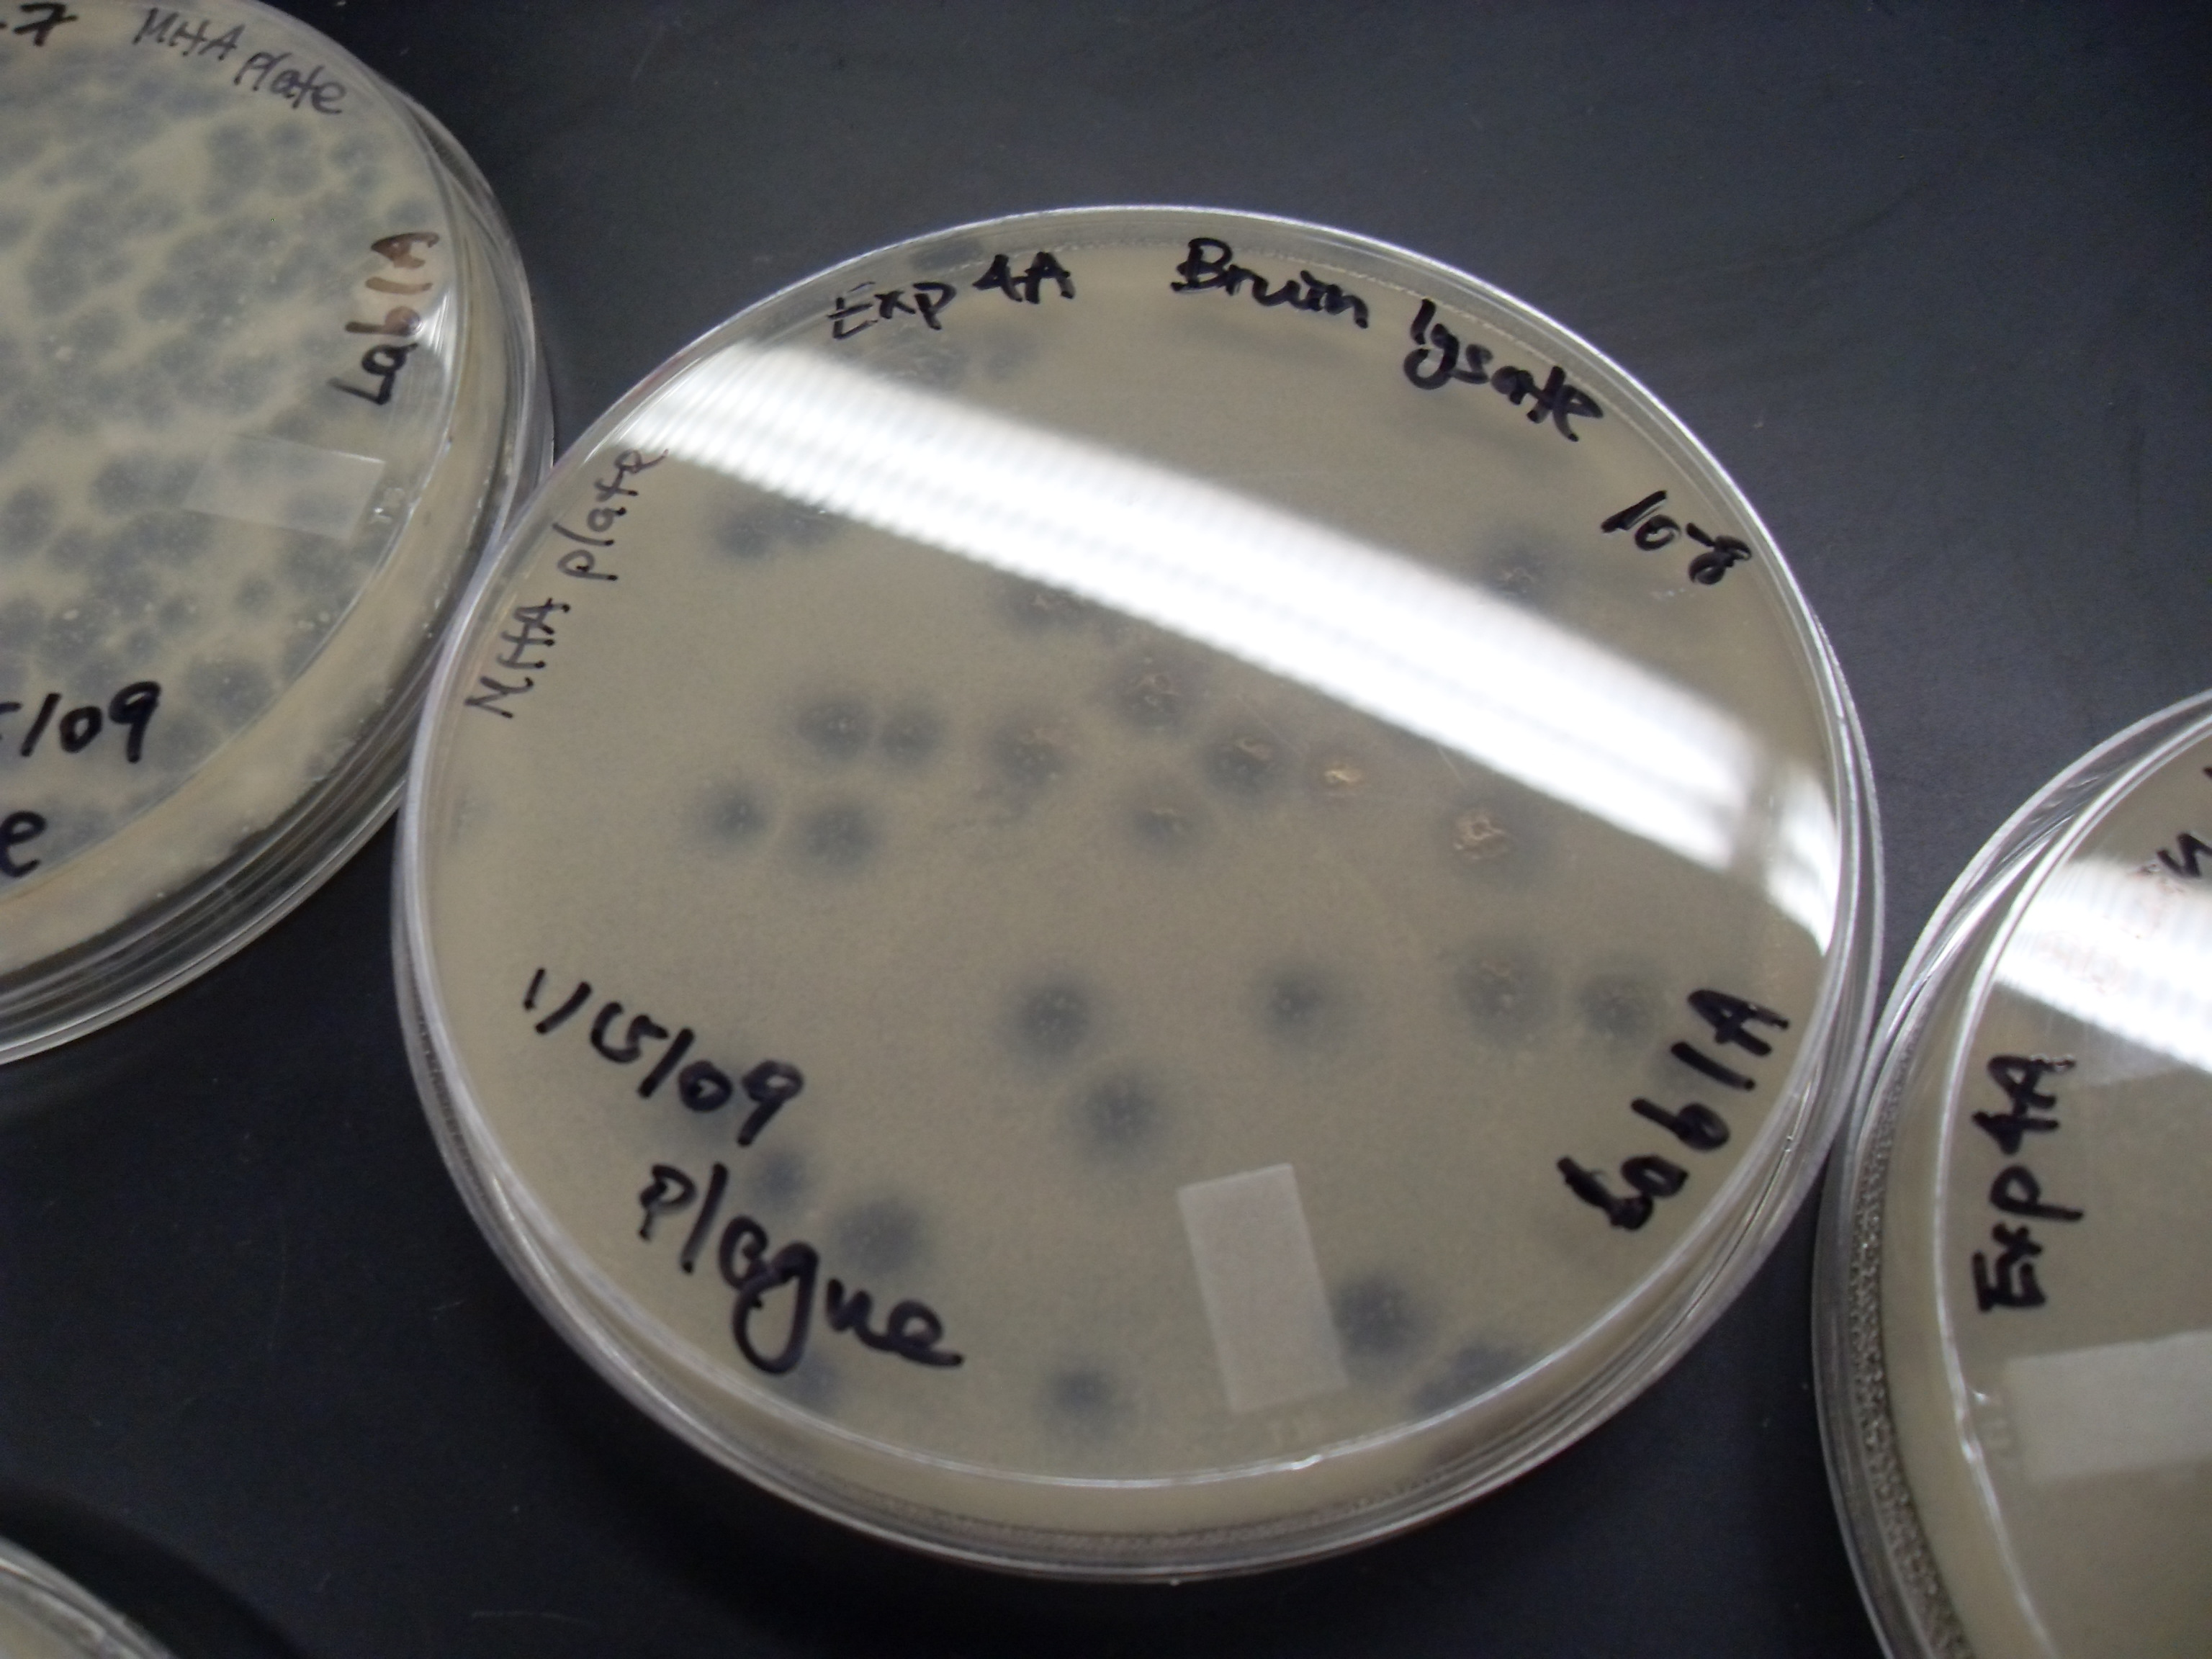
<p>what are plaques&nbsp;</p>

1/26
Looks like no tags are added yet.
Name | Mastery | Learn | Test | Matching | Spaced |
|---|
No study sessions yet.
What is a bacteriophage or phage
a virus which infects and replicates within a host bacterium
what bacteriophage do we use
T4
why do we use T4 bacteriophage
to demonstrate phage relication and determine the concentration of virus
concentration of virus
number of phages per unit volume
phages are also known as
coliphages
why is a phage also known as a coliform
since its host is the gram-negative bacterium Escherichia coli.
How to perform the T4 bacteriophage test
aseptically transfer a pure suspension of coliphage to a broth culture containing the host bacterium
transfer this mixture to a warm, semisolid or soft (0.5%) agar
Use that agar as an overlay on the surface of a solid (1.5%) agar in a petri dish
when a lawn of E.coli grows on the top layer of soft agar, the bacterial cells that have been infected with the coliphage will undergo a
lytic cycle
What happens during a lytic cycle
virus pre-empts normal cell activities, forcing the host to use its biosynthetic enzymes and structures (e.g ribosomes) to produce new viral proteins and nucleic acids. This hijacks the host cell machinery to reproduce the virus. These newly synthesized viral compoents are then assembled as complete phages or virions
wha happenswhen newly synthesized phages or virions are made
the bacterial host cell will eventually lyse and release the new virions to infect other neighboring cells. These lyse cells become visible as plaques
what are plaques
lysed cells that are visible as clear zones
Much like colony-forming units are initiated by one bacterial cell, these plaque-forming units (PFU) begin as
one virion infecting one bacterial cell
By counting the number of PFU and knowing the dilution of the viral suspension that was plated, it is possible to calculate the
original concentration of virus (PFU/ml) using the following formula
original phage density formula
#PFU/volume of virus suspension plate * dilution
CFU formula (mL)
CFU * dilution/ volume plated (ml)
what are viruses
obligate intracellular parasites that take over the host cell machinery to make more copies of themselves
animal viruses
viruses that infect humans and other animals
how do we know about viruses
from studying viruses that infect bacteria as their
hosts, ‘bacteriophages
100 uL equals
0.1 mL
why do we let the three tubes sit undisturbed for 15 minutes
will allow the bacteriophage adequate time to adsorb and penetrate the e.coli host cells
a dliution plate is only countable when
there are 30-300 PFU
why was a soft agar overlay, that contained a lower concentration of agar, used in this assay?
Allows the movement of viruses to the neighboring bacterial cells. The result are visible plaques as a result of the lytic cycle on the bacterium lawn
What is a plaque? What is a PFU?
A plaque is a clear zone on a bacterial lawn where viruses (bacteriophages) have infected and killed bacterial cells.
A PFU (Plaque Forming Unit) is a single infectious virus particle that is capable of forming one plaque. It’s used to quantify the number of active viruses in a sample
how are plaques/pfu formed
A bacteriophage infects a single bacterial cell.
The phage replicates inside the cell and lyses (bursts) it.
New phages released from that cell infect nearby cells.
This cycle repeats, creating a visible cleared area called a plaque.
Each plaque corresponds to one original infectious phage, counted as 1 PFU.
How do you record the results of a plate which has fewer than 30 PFU? More than 300 PFU?
You don’t
Describe why a 15 minute adsorption (attachment) period is included in the procedure.
will allow the bacteriophage adequate time to adsorb and penetrate the Escherichia coli host cells

explain this process
0.1 mL of phage is put into V1, which contains 9.9 ml of steril TSB
0.1 mL of V1 is put into V2. This makes the dilution 10-2
0.1 mL of V2 is put into V3. This makes the dilution 10-3
After put stock culture of e.coli into each. Then transfer V1 into E1. V2 into E2 and V3 into E3.
Let tubes rest for 15 minutes and get a soft agar tube.
Pour the mixture onto plate 1 from E1. This is 10-2 plate.
repeat this step with E2 and E3, making 10-3 and 10-4 plates